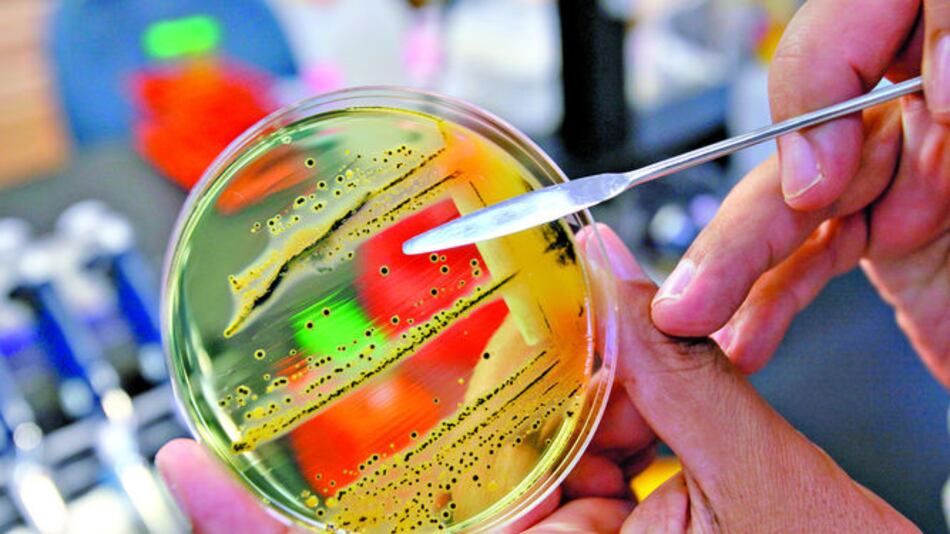
Urgen nuevos antibióticos

La Organización Mundial de la Salud (OMS) publicó el lunes pasado una lista de 12 familias de bacterias resistentes a los tratamientos actuales y contra las que es urgente desarrollar nuevos antibióticos, debido a su peligrosidad.
El riesgo para la salud es incluso “crítico” en el caso de tres familias de bacterias , resistentes incluso a los antibióticos más recientes y causantes de la mayoría de infecciones en los centros hospitalarios.
Los llamados “patógenos prioritarios” provocan infecciones en la sangre, los pulmones, el cerebro y también en el tracto urinario, que pueden ser mortales.
“La resistencia a los antibióticos está creciendo y nos estamos quedando rápidamente sin opciones de tratamiento”, dijo Marie-Paule Kieny, asistente del director general de la OMS.
“Si dejamos este asunto a las fuerzas del mercado, los nuevos antibióticos que necesitamos urgentemente no se desarrollarán a tiempo”, señaló esta experta.
La OMS emplaza a los gobiernos a incentivar la financiación pública y privada para luchar contra estas “superbacterias”.
La agencia de la ONU ha advertido con anterioridad de que si no se actúa, el mundo está abocado a una era de “posantibióticos”, en la que infecciones comunes y pequeñas heridas volverán a ser mortales.
Las bacterias pueden volverse resistentes cuando el paciente no toma correctamente los antibióticos.
Estas infectan mediante el contacto directo con otras personas, los animales, el agua y el aire.
Cuando los antibióticos más usuales no funcionan, se recurre a otros tratamientos más caros y largos, que a menudo requieren la hospitalización.
Las bacterias destacadas por la OMS fueron seleccionadas, entre otros criterios, según el grado de severidad de las infecciones que causan, la facilidad con que se propagan y cuántos antibióticos eficaces quedan para hacerles frente.
La lista está dividida en tres categorías, según su prioridad: crítica, alta y media. La primera incluye “superbacterias” resistentes a los antibióticos carbapenémicos, un recurso de última oportunidad para las infecciones potencialmente mortales que a menudo se propagan en los hospitales, asilos y entre pacientes que necesitan respiradores y catéteres.
En enero, una mujer estadounidense murió debido a una infección resistente a los 27 antibióticos disponibles, causada por el germen Enterobacteriaceae, incluido en la lista de la OMS.
La segunda y tercera categorías incluyen bacterias que causan enfermedades “más comunes”, como gonorrea y salmonela.
La lista será examinada junto a expertos en materia de salud del G20, reunidos en Berlín esta semana.
“Los nuevos antibióticos contra esta lista prioritaria de patógenos ayudarán a reducir el número de muertes debido a las infecciones resistentes en el mundo”, dijo Evelina Tacconelli, de la Universidad de Tuebingen en Alemania, que participó en su elaboración.
En septiembre, un estudio afirmó que las bacterias resistentes podrían “matar a hasta 10 millones de personas por año de aquí a 2050”.
En la lista de la OMS no se incluyó la tuberculosis porque ya existen programas de financiación para desarrollar nuevos antibióticos.